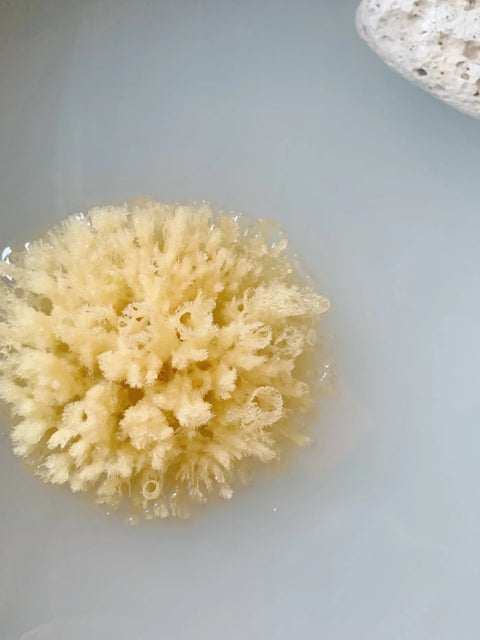
Natuurlijke spons

Mellow Mind

Natuurlijke spons
Local pick-up is momenteel niet beschikbaar
100% natuurlijke badspons die zacht aanvoelt op de huid en kan worden gebruikt door volwassenen, kinderen en baby's.
Een natuurlijke spons is, zoals het woord beschrijft, een spons die door de natuur is gemaakt en geen kunstmatig geproduceerde spons. De spons groeit in de Middellandse Zee op een diepte van 10 tot 80 meter. Hier duiken vissers naar beneden en halen een klein deel van de spons op, maar laten de wortel van de natuurlijke spons achter zodat de spons op de zeebodem kan blijven groeien. Een natuurlijke spons is hypoallergeen, ongelooflijk duurzaam en kan een lange levensduur hebben als je hem goed verzorgt en tussen gebruik door laat drogen. Omdat de spons 100% natuurlijk is, kan deze variëren in grootte en vorm.
Betalen
Alle prijzen zijn inclusief btw. Betalen gebeurt altijd via een beveiligde verbinding: met kredietkaart of bancontact, jij kiest!
Verzenden
Verzenden binnen België kan op onze kosten (studio paus trakteert!) voor bestellingen vanaf 150 euro. Ligt het totaalbedrag lager? Dan betaal je voor een verzending naar een Belgisch adres of ophaalpunt 6,95 euro.
Meer details ontdek je hier.
Retourneren
Elke bestelling wordt met eindeloos veel liefde en een stevige portie passie jullie richting uitgestuurd. Ben je toch niet 100% overtuigd van wat je ontvangt? Dan kan je het zorgvuldig terugbrengen of -sturen.
Alle geldende voorwaarden en meer info vind je hier.